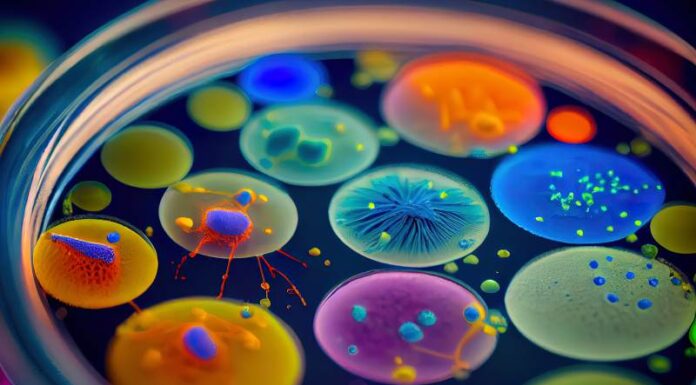

Stan zapalny ucha środkowego – intensywna faza choroby
Stan zapalny ucha środkowego - intensywna faza choroby
Rozpoznanie problemu
Zaraz po tym, jak dziecko zacznie skarżyć się na ból ucha, a maluch lub dorosły poczuje nagłe dolegliwości, często towarzyszące intensywnemu przeziębieniu, warto wiedzieć, że to może być początek stan zapalnego ucha środkowego. Ta bolesna dolegliwość, zwana również ostym zapaleniem ucha środkowego, może przysporzyć wielu trudności,...
Czy petting jest bezpieczny w okresie połogu
Zrozumienie potrzeb intymnych kobiet w okresie połogu to Kwestia delikatna, wymagająca wrażliwego podejścia, ale też gruntownej wiedzy. Nie każdy wie, że czas po urodzeniu dziecka jest dla świeżo upieczonej mamy momentem wyjątkowego zmęczenia, emocjonalnego wahania i intensywnej transformacji fizycznej. Potrzeba bliskości i czułości może mieszać się z obawami o bezpieczeństwo wznowienia aktywności seksualnej. Właśnie...
Studium komórkowe – badania i znaczenie w biologii komórki
Odkąd człowiek zaczął używać mikroskopu, fascynacja tym, co dzieje się na poziomie komórkowym, nie przemija, ale skręca i wiśnie jak DNA w naszych chromosomach. Wielu z nas być może pamięta te szkolne dni pełne zdumienia, gdy po raz pierwszy zerknęliśmy przez okular mikroskopu, aby dostrzec niewidzialne dotąd tajemnice życia; było to jak odkrywanie zupełnie...
Linie na paznokciach i ich znaczenie – odkryj, co mówią o twoim zdrowiu
Często bywa tak, że najmniejsze sygnały wysyłane przez nasze ciała mogą być jak drogowskazy na ścieżce zdrowia, które niepostrzeżenie prowadzą nas do odkrycia czegoś nowego o naszym organizmie. Jednym z takich subtelnych, acz wnikliwych sygnałów są linie na paznokciach – owe eteryczne wzory, które mogą wyglądać jak artystyczne zdobienia, ale nierzadko są ekspresyjnym językiem...
Jak zwalczyć suchy kaszel u dzieci – praktyczne metody Metody łagodzenia suchego kaszlu u najmłodszych Domowe sposoby na walkę z suchym kaszlem młodych pacjentów Jak zaradzić suchemu kaszlowi u dziecka – sprawdzone...
Rozterki rodzicielskie potrafią być nie lada wyzwaniem, szczególnie gdy dotykają zdrowia naszych pociech. Jednym z częstych zmartwień jest suchy kaszel, który potrafi skutecznie zakłócić spokojny sen zarówno dzieci, jak i ich opiekunów. Szukając skutecznych rozwiązań na to uporczywe dolegliwość, warto zwrócić uwagę na praktyczne i często niedoceniane metody, które mogą przynieść ulgę naszym maluchom.
Domowe...
Zastosowanie aspiryny w zapobieganiu komplikacji ciążowych
Mimo że aspiryna, zwana potocznie "królową leków", przechodziła przez wieki swoistą ewolucję odkryć i zastosowań, dziś znajduje się ona na ustach specjalistów z dziedziny medycyny okołoporodowej. Niegdyś nieodłączny składnik apteczek, lekarstwo na ból głowy i gorączkę, teraz aspiryna podsuwa swoje nowe oblicze – jako potencjalny agent profilaktyczny dla przyszłych matek borykających się z ryzykiem...
Metody terapeutyczne stosowane u dzieci z zaburzeniami ze spektrum autystycznego
Wśród niuansów dzisiejszej medycyny rozwojowej, terapie przystosowane do potrzeb dzieci z zaburzeniami ze spektrum autystycznego wybijają się jako dziedzina wymagająca wyjątkowego zrozumienia i cierpliwości, doprawiona szczyptą innowacyjności. Celem terapii jest wzbudzenie i zaspokojenie potrzeb malucha, jednocześnie umożliwiając mu pełne i harmonijne funkcjonowe w społeczeństwie. Zdaję sobie sprawę, że porywanie się na tak ogromne wyzwanie...
Testy prenatalne dostępne dla wszystkich pacjentów
Widzisz, fascynujące jest to, jak nieuchwytnie strzelisty może być postęp technologiczny, zwłaszcza gdy spoglądamy przez pryzmat nowoczesnej medycyny. Kiedy zbliżasz się do przełomowego okresu macierzyństwa, a pulsujące emocje towarzyszące oczekiwaniu na nowego członka rodziny mieszają się z troską i ciekawością, współczesna diagnostyka oferuje ci bezcenne usługi. Chodzi o testy prenatalne, które dziś są szerzej...
Spektrum autystyczne w życiu dorosłym – geneza i symptomy
Rozważając niezwykle różnorodny świat ludzkich doświadczeń, natrafiamy na tematykę spektrum autystycznego – zagadnienie, które w życiu dorosłych osób przejawia się w sposób wysoce indywidualny, zależny od wielu czynników i wyjątkowo subtelny w swoich manifestacjach. O ile w dzieciństwie znaki te mogą być dostrzegane jako wyzwania rozwojowe, to u osób dorosłych symptomy często mogą pozostawać...
Informacje na temat astmy dziecięcej które powinniście znać
Zrozumienie astmy dziecięcej jest kluczowe dla rodziców i opiekunów, którzy zmagają się z lękiem i niepewnością towarzyszącymi diagnozie tej przewlekłej choroby dróg oddechowych u najmłodszych. Potrafi być ona jak nieproszony gość, który niespodziewanie pojawia się w najmniej oczekiwanych momentach, wywołując zdenerwowanie, a czasem wręcz panikę. Przekonanie się, jakimi ścieżkami porusza się ta choroba, z...